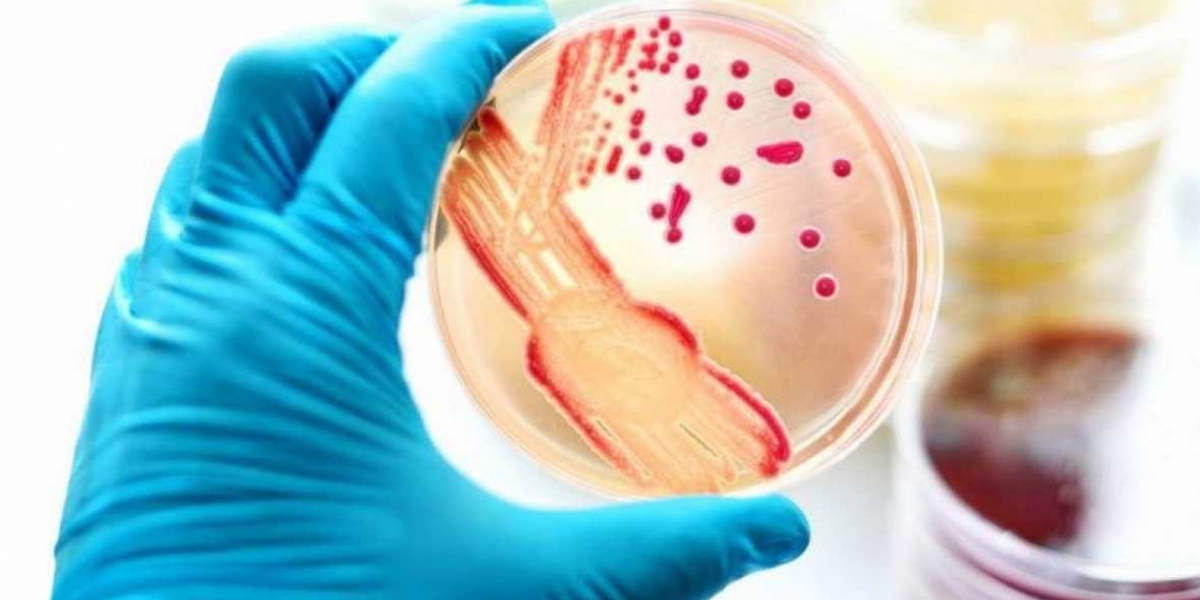
Archivo La gonorrea afecta a más de 70 millones de personas en el mundo.

OMS alerta que la gonorrea es cada vez más resistente a los antibióticos
Días antes de que se inicie en Brasil el Congreso Mundial de las enfermedades de transmisión sexual y el VIH, del 9 al 12 de julio, la Organización Mundial de la Salud publicó un estudio que analiza la gonorrea en 77 países.
Los resultados del estudio son alarmantes: esta enfermedad contagiosa de transmisión sexual es cada vez más resistente a los antibióticos, lo que dificulta, e incluso, hace imposible que, en algunos casos, se pueda tratar.
"La bacteria que causa la gonorrea es especialmente astuta. Siempre que utilizamos un nuevo tipo de antibióticos para tratar esta infección, el microbio aprende a resistir al fármaco", dijo la responsable del departamento de Reproducción Humana de la agencia sanitaria de la ONU, Teodora Wi.
Según el estudio, esta especie de inmunidad a los antibióticos, si bien se da como un fenómeno natural, se acrecenta en gran medida por el indebido uso de los fármacos y el mayor número de infecciones que se vienen presentando.
Se estima que más de 70 millones de personas en el mundo están infectadas con gonorrea, de las cuales 35,2 viven en el Pacífico occidental, 11,4 millones en el sudeste asiático, mientras que en las Américas hay alrededor de 11 millones, entre otros.
Según el estudio, este aumento desmedido se viene presentando por cuenta del comportamiento sexual inseguro, es decir, no utilizar sistemas de protección como el condón. Una particularidad que aumenta esta enfermedad es el crecimiento del turismo y los sistemas de detección poco efectivos que existen.
Tags
Más de
Error en combate: Kuwait derriba tres aeronaves estadounidenses
Los F-15 participaban en la ofensiva militar contra Irán cuando fueron alcanzados accidentalmente.
Arde el Líbano: Israel responde a Hezbolá tras el abatimiento del líder Jameneí en Irán
Israel inició bombardeos masivos en todo el Líbano tras una lluvia de misiles lanzada por Hezbolá hacia el sur de Haifa.
Israel desmiente ataque contra oficina del primer ministro, Benjamín Netanyahu
Tras la dada de baja del dictador, el ayatolá Alí Jameneí, las fuerzas iraníes declararon la guerra a Israel y a Estados Unidos.
Israel confirma la muerte del líder supremo iraní Alí Jamenei
Netanyahu asegura que su cadáver fue hallado en un búnker
Operación de Israel en territorio iraní deja 53 niñas sin vida
Las fuerzas armadas informaron de la destrucción de defensas avanzadas en el oeste del país durante la ofensiva conjunta con Estados Unidos.
Maduro se queda sin fondos para pagar a su abogado tras bloqueo de EE. UU.
La oficina de control de activos extranjeros revocó la licencia que permitía enviar dinero desde Venezuela para su defensa en Nueva York.
Lo Destacado
A la cárcel hombre que intentó asesinar a su exmujer con escopeta en Zona Bananera
La Fiscalía logró la medida de aseguramiento tras demostrar que el procesado no sólo hirió a la mujer en el pecho y una mano, sino que la sometió a años de maltrato físico, psicológico y económico.
Hasta las 4 pm de este lunes, hay jornada para que jóvenes definan su situación militar
La Alcaldía a través de la Secretaría de Seguridad y en articulación con el Ejército, desarrolló esta iniciativa para atender trámites y brindar información personalizada.
Siniestro vial y doble homicidio: el saldo del fin de semana en Santa Marta
Tres personas perdieron la vida en hechos aislados ocurridos entre la madrugada del sábado y el domingo.
Alerta electoral: Colombia llega a las urnas entre amenazas de fraude y violencia armada
Las autoridades han detectado movimientos inusuales de inscripción de cédulas en municipios claves del Caribe y el Catatumbo.
Aparatoso accidente en Santa Marta: taxi terminó volcado tras fuerte choque
El siniestro ocurrió en la Troncal del Caribe, a la altura del hotel Shana Plus.
Descubren en Argentina restos de dinosaurio gigante
Investigadores afirman que los huesos permanecieron en el lugar por más de 200 millones de años.


































